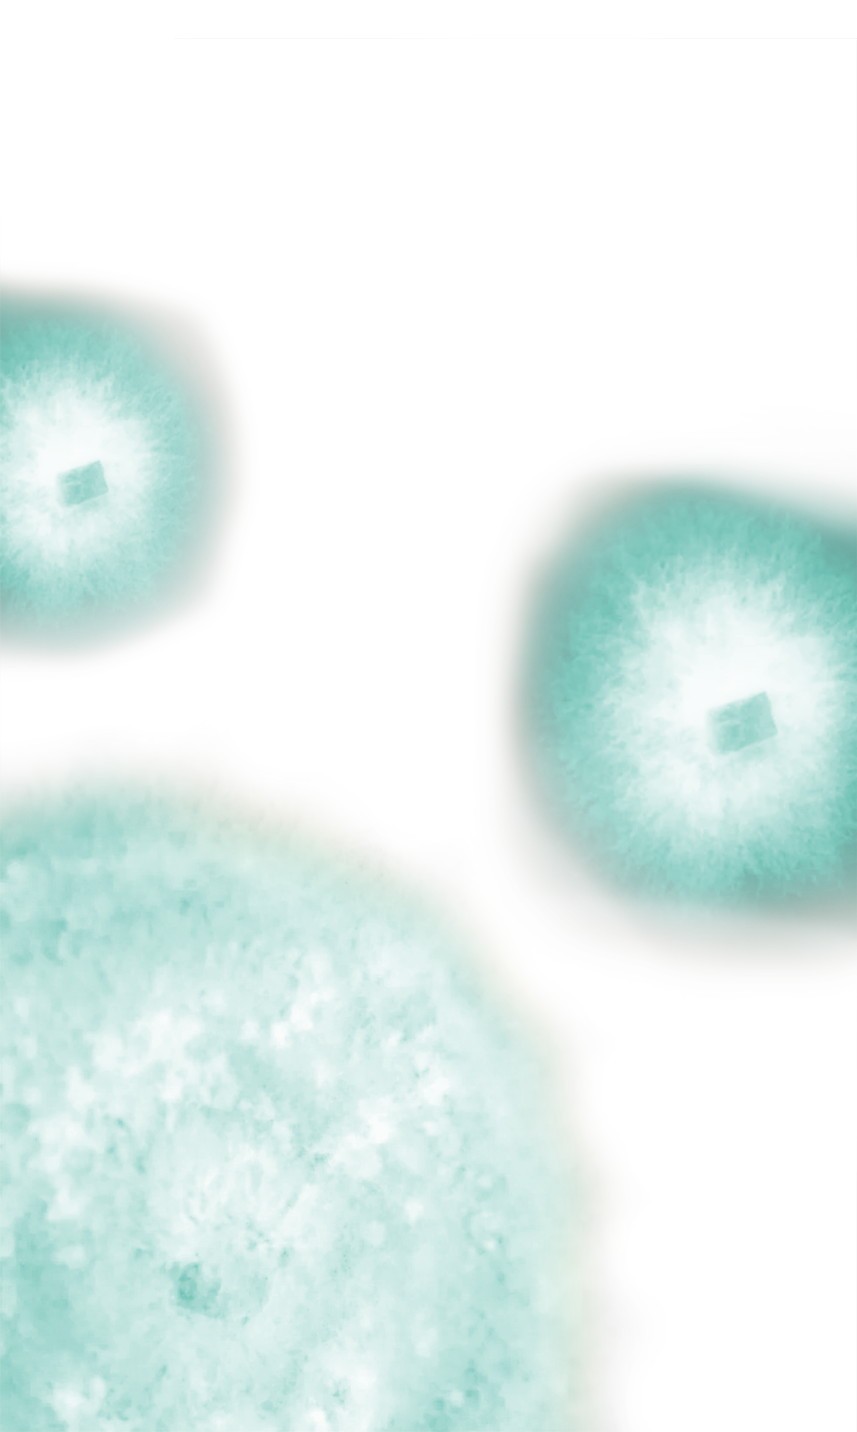
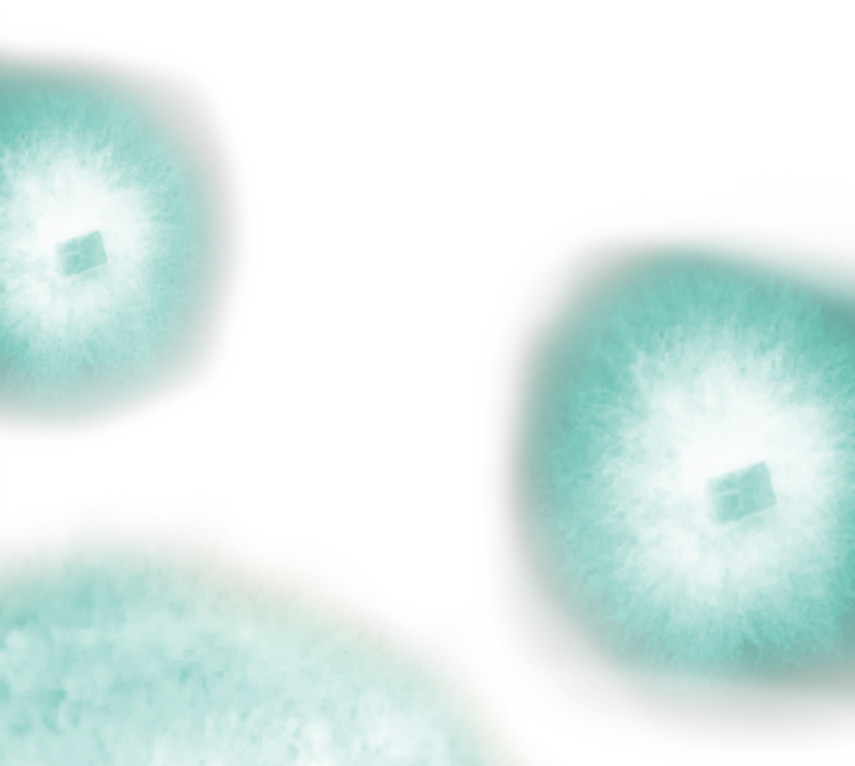

Грибы
—
—
мицелий высших грибов, выращенный в ферментере в экологически чистых условиях глубинного культивирования. Источник редких биологически активных соединений.
Во все времена грибы считались ценным пищевым ресурсом и источником лекарственных соединений. Их широко используют в народной медицине.
Грибы содержат все незаменимые для человека аминокислоты
Обеспечивают организм «хорошими» жирами
Оказывают положительное влияние на микрофлору кишечника
Источник полноценного белка
Источник полиненасыщенных жирных кислот
Источник пищевых волокон
Уникальный химический состав
Грибы содержат ценные биологически активные вещества, обладающие специфическими свойствами



Антиоксидантное
Иммуномодулирующее
Противоаллергическое



Детоксикационное
Противовоспалительное
Регенеративное



Свойства грибов

Кардиопротективное

Антибактериальное

Антилипидемическое

Противовирусное

Гипогликемическое
Для того, чтобы сделать редкие виды грибов, обладающие уникальными лечебными свойствами, доступными для широкого использования, биотехнологи научились выращивать их в лабораторных и промышленных условиях
Плодовое тело, состоящее из переплетенных нитей грибницы
Забор материала для выращивания грибов в лаборатории методом глубинного культивирования
Грибница (мицелий) с формирующимся плодовым телом

‣
‣
‣



Технология выращивания грибов методом глубинного культивирования позволяет производить уникальный высококонцентрированный биопродукт — биомассу грибов с метаболитами
Грибница (мицелий)
Биологически активные вещества, которые продуцируют грибы (метаболиты)
‣
‣







Современное оборудование позволяет использовать не только гриб, но и ценные вещества, которые эти грибы производят (метаболиты)

Content Oriented Web
Make great presentations, longreads, and landing pages, as well as photo stories, blogs, lookbooks, and all other kinds of content oriented projects.
Почему
использование грибов, выращенных биотехнологическим способом более предпочтительно, чем собирание грибов в лесах?
Экологичность
Доступность редких видов грибов
Как известно, грибы обладают способностью «впитывать» в себя все, что находится рядом, в том числе опасные для человека соединения. Грибы, выращенные биотехнологическим методом, не содержат тяжелых металлов и радионуклидов, употребление таких грибов безопасно
Благодаря глубинному культивированию появилась возможность употреблять в пищу грибы с уникальными целебными свойствами, которые сложно встретить в лесу или которые занесены в Красную книгу


Первый в России коммерческий продукт на основе выращенных глубинным способом высших грибов
Грибы имеют паспорта штаммов и не являются генетически модифицированными
Использование специальных сред, позволяет выращивать редкие виды грибов, обладающих уникальными лечебными свойствами
Экологический контроль грибной биомассы и продуктов их метаболизма
Содержит метаболиты, включающие широкий спектр специфических биологически активных веществ
Ready-to-use формы продукции
Высокая биодоступность ценных веществ за счет высокого содержания водорастворимых метаболитов
Преимущества
грибной продукции компании Артлайф


№1